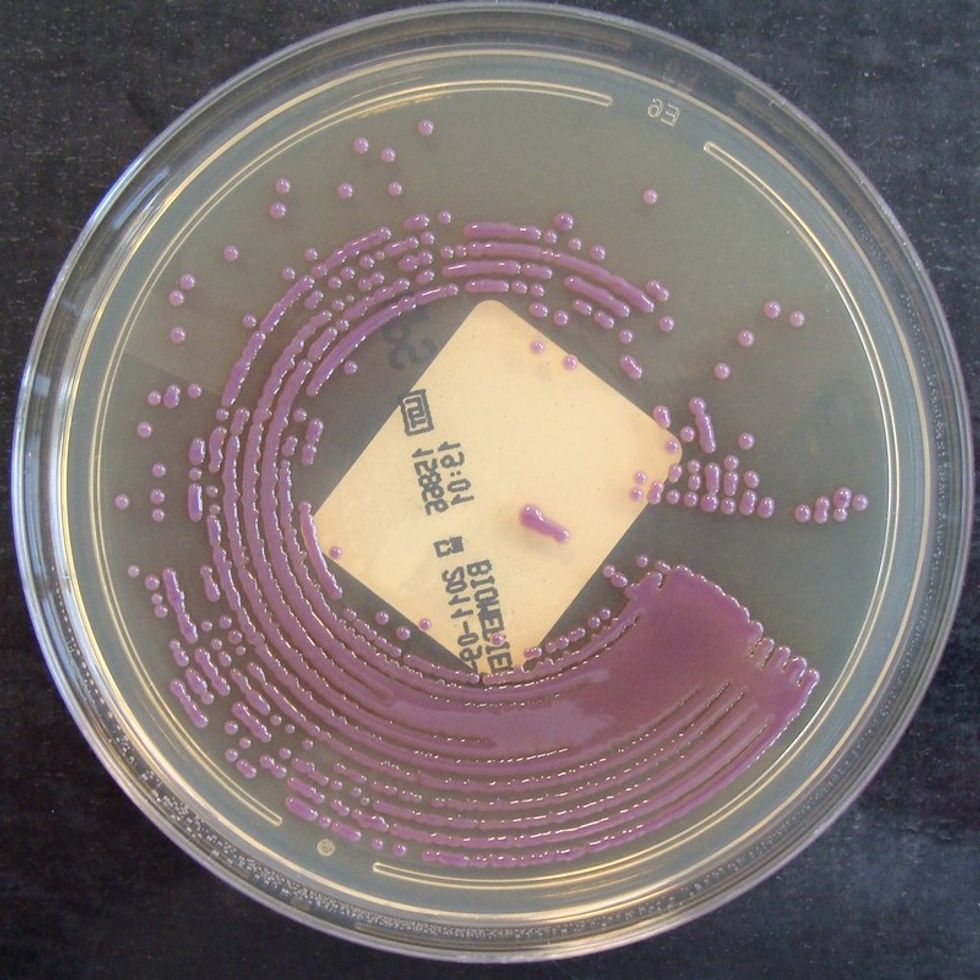

Just in time for swimsuit season, federal researchers are touting a faster, more accurate water-quality test to keep beaches open and people healthy.
But it's expensive, and most of the nation's cash-strapped cities and counties can afford it.
Local officials traditionally check for bacteria in ocean and lake water with tests that take about 24 hours to complete. Now the U.S. Environmental Protection Agency is recommending testing at the molecular level – tagging DNA and counting bacteria – which provides results within hours.
"Water quality can change significantly in 24 hours. This way we're identifying threats to human health almost immediately," said Meredith Nevers, a research ecologist with the U.S. Geological Survey who is studying the EPA's new DNA test.
An estimated 3.5 million people get sick every year after a trip to the beach because of E. coli or other pathogens from sewage overflows, spills and polluted runoff, according to the EPA. Exposure can cause gastrointestinal illness, skin rashes and infections.
About 43 percent of beaches along the East and West coasts and the Great Lakes had at least one water-quality advisory in 2011, according to EPA data.
Counties and cities test beaches routinely – often weekly but depending on the location and season. Beaches also are tested after spills to determine when they can be reopened.
Slow results
Traditional tests involve waiting 24 hours to allow E. coli, coliform or enterococci to grow in a water sample, then counting the colonies. That means decisions to close down beaches are based on samples collected the day before.
The new method speeds up DNA replication. Researchers then use fluorescent probes to see how many bacteria are present in a water sample by counting the DNA copies that fragmented. Other same-day tests are in various stages of research, but all generally use two steps: capturing microbes and tagging them so they can be counted.
Comparing the new method to the culture-based tests at Lake Michigan beaches, Nevers and colleagues concluded that beach closures and illness rates "could be minimized." They couldn't predict how many unnecessary closings or illnesses it would prevent, but it would be "significant," Nevers said.
"Rapid testing is great – the faster the results, the better," said Shannon Briggs, a toxicologist at the Michigan Department of Environmental Quality, which works with communities throughout the state on beach testing. "The goal is to keep beaches open all the time and keep people safe and this will help."
But it's not cheap.
DNA testing requires new labs and newly trained staff – a significant hurdle for cities and counties. Nevers estimated the new tests would cost about twice as much as the old ones.
Universities throughout Michigan are partnering with some coastal communities to help get the ball rolling.
Only Racine
The only community using the method right now to make beach safety decisions is Racine, Wis. The city received clearance last year from the EPA to use the DNA test on its two beaches that frequently exceed safe bacteria counts after years of testing it, said Julie Kinzelman, a research scientist at the Racine Health Department.
"We used to have to say, 'well, you swam yesterday and now we know the water wasn't clean. Sorry we couldn't tell you in time,'" Kinzelman said.
Racine still uses culture tests to check the reliability of the DNA testing. Kinzelman said over the years the two different tests have been at about 90 percent agreement.
Racine's lab was purchased with grant money, and it has expanded with grant and city money. Kinzelman had to be trained and now uses college students to help run the tests. She credits the city's beach pride for being on the cutting edge of beach testing.
"Beaches are our identity," she said. "We're Racine on the lake."
Too costly for Chicago, California
But in Chicago, Cathy Breitenbach, director of lakefront operations for the city's Park District, said it's not economical.
"We have 24 beaches, we'd have to move up and down 26 miles of coastline, take samples and get them to a lab," Breitenbach said.
"We'd have to start at 2 in the morning" in order to take advantage of the same-day benefits.
No one is using the rapid method in California, said John Griffith, a marine microbiologist at the Southern California Coastal Water Research Project, a research institute that studies coastal pollution. "We barely have money to do our regular culture testing," he said.
The EPA should subsidize the DNA test method for states, said Steve Fleischli, water program director at the Natural Resources Defense Council, an environmental advocacy group.
"People want to know what the water is like when they're in it, not what it was like days beforehand," Fleischli said.
But Griffith said rapid testing only makes sense at certain beaches.
"If a beach never has a problem, or if you have a chronically contaminated beach, you don't need a rapid answer and it'd be hard to justify this cost," Griffith said.
Griffith and colleagues are working on different rapid testing methods with communities along Southern California's coast. One method, still in the testing phase, is a mobile DNA sampler that sends results to the lab directly from the field.

Predicting water quality
Some beach managers are pairing testing with predictive software, which projects water quality based on weather and water conditions. Briggs said the software is about 90 percent accurate in most Michigan locations.
"Before it was always a guess. Now we're getting accurate information, and getting it faster," Briggs said.
And it seems to be working. Michigan beaches were open 97 percent of the time in 2011, according to the EPA. Chicago is focusing on predictive modeling at 15 beaches and the decisions were more accurate than those made by the culture tests, Breitenbach said.
Predictive modeling, however, isn't used in many ocean communities, where larger waves and less summer rainfall make it much less useful than in the Great Lakes, Griffith said.
The DNA test is included in a set of voluntary recommendations the EPA released last November when it updated water-quality criteria. The EPA's guidelines recommended that states test beach water and notify the public more quickly.
But the EPA's new proposed 2014 budget would eliminate federal funding for beach monitoring completely – a $9.9 million takeaway.
States and others that used the funding "now have the ability and knowledge to run their own programs without federal support," according to the budget proposal.
















